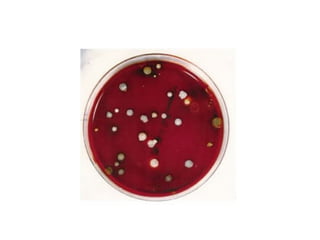

Este documento describe las pruebas requeridas antes, durante y después de las transfusiones de sangre para garantizar su seguridad. Incluye pruebas de tipificación sanguínea, detección de enfermedades infecciosas, investigación de reacciones transfusionales y prevención de aloinmunización. El objetivo principal es evitar errores que puedan causar reacciones adversas en el paciente recepto